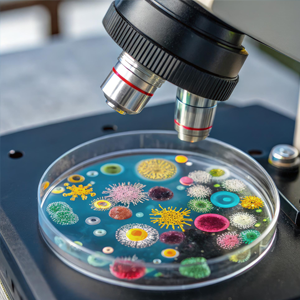
Microbiology

We’re Aivanta Labs LLC — a modern clinical laboratory delivering precise and reliable diagnostic testing for healthcare providers and patients.
With advanced technology, strict quality control, and fast turnaround times, we provide trusted results that support better medical decisions.
Precision Diagnostics • Advanced Laboratory Technology • Trusted Healthcare Partner
Aivanta Labs LLC delivers advanced clinical testing services designed to support accurate diagnosis, effective treatment, and better patient outcomes. Our laboratory combines cutting-edge technology with strict quality standards to ensure reliable results every time.
Comprehensive blood analysis including Complete Blood Count (CBC), anemia screening, and clotting studies. Our hematology services help detect infections, blood disorders, and overall health conditions with precision.

Accurate testing of glucose levels, kidney and liver function, lipid profiles, and metabolic panels. Our chemistry diagnostics provide essential insights into organ health and chronic disease management.

Identification and analysis of infectious agents including bacteria, viruses, and fungi. Our microbiology testing supports accurate diagnosis and targeted treatment planning.
Advanced PCR-based and genetic testing services for infectious diseases and specialized diagnostic needs. Molecular diagnostics enhance early detection and personalized treatment strategies.

Experienced laboratory scientists, technicians, and support staff committed to delivering accurate and timely diagnostic results.
High-volume laboratory capacity powered by advanced automation and strict quality control systems.
Supporting physicians, hospitals, and healthcare providers with reliable diagnostic insights.
Rigorous quality assurance protocols ensure precise and dependable laboratory results.
Trusted by clinics, physicians, and medical institutions for consistent and compliant laboratory services.
Whether you're a healthcare provider seeking laboratory partnership or a patient with questions about our testing services, our team is here to assist you with prompt and professional support.
Precision Diagnostics • Advanced Laboratory Technology • Trusted Healthcare Partner